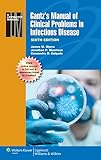
Amazon cover image

Gantz's manual of clinical problems in infectious disease / [edited by] James W. Myers, Jonathan P. Moorman, Cassandra D. Salgado.
Series: Lippincott manualPublication details: Philadelphia : Wolters Kluwer Health/Lippincott Williams & Wilkins, 2013.Edition: 6th edDescription: xv, 639 p. ; 25 cmISBN:- 9781451116977
- Manual of clinical problems in infectious disease [Portion of title]
| Item type | Current library | Home library | Collection | Call number | Materials specified | Copy number | Status | Date due | Barcode | |
|---|---|---|---|---|---|---|---|---|---|---|
| AM | PERPUSTAKAAN HOSPITAL CANSELOR TUANKU MUHRIZ | PERPUSTAKAAN HOSPITAL CANSELOR TUANKU MUHRIZ KOLEKSI AM-P. HOSPITAL CANSELOR TUANKU MUHRIZ | - | WC39.G211 2013 9HUKM (Browse shelf(Opens below)) | 1 | Available | 00002091998 |
Browsing PERPUSTAKAAN HOSPITAL CANSELOR TUANKU MUHRIZ shelves, Shelving location: KOLEKSI AM-P. HOSPITAL CANSELOR TUANKU MUHRIZ Close shelf browser (Hides shelf browser)

|

|

|

|

|

|

|
||
| WC39.C6403 2009 9HUKM Clinical and diagnostic virology / | WC39.E207o 1999 9HUKM Oxford handbook of tropical medicine / | WC39.F438 2001 9HUKM The 5-minute infectious diseases consult / | WC39.G211 2013 9HUKM Gantz`s manual of clinical problems in infectious disease / | WC39.G661 2012 9HUKM Gorbach`s 5-minute infectious diseases consult / | WC39.H2361 2001 Handbook of infectious diseases / | WC39.I35 2007 9HUKM In a page : infectious disease / |
This book includes online access at http://solution.lww.com, please refer library staff for the password.
There are no comments on this title.
Log in to your account to post a comment.